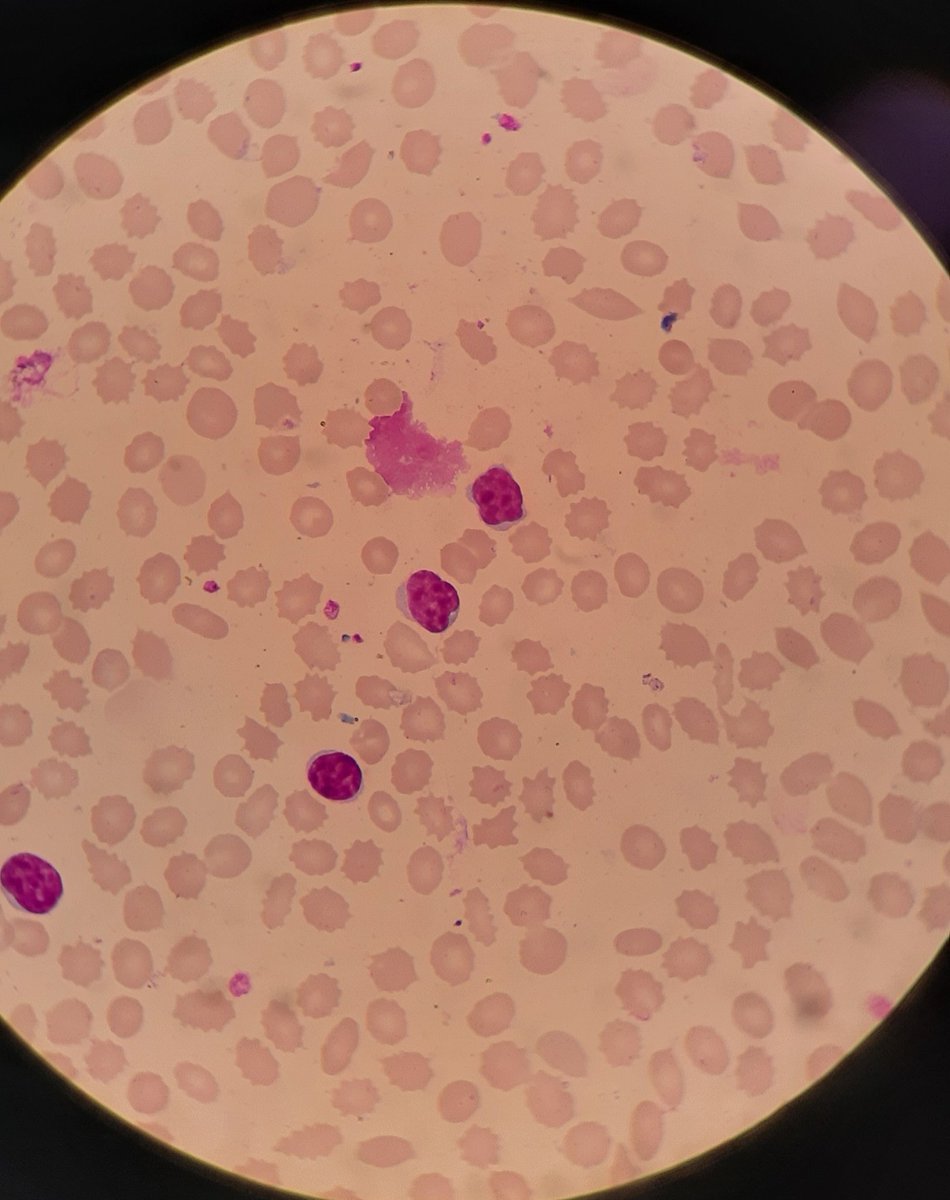
Soccer ball appearance of lymphocytes in CLL, suggestive of B cells.
#hemepath #PathTwitter

Dr. Hajra Mehdi
@hajra_mehdi
AAMC : 15553875 | 2025 residency applicant | 🇮🇳 IMG | ECFMG Certified | #Match2025 | CARPEing one DIEM at a time
ID: 1287087356214796288
25-07-2020 18:08:49
91 Tweet
211 Takipçi
400 Takip Edilen









Everyday without a rejection is a good day in my books 🥹 Still waiting on the 1st IV. Hopes up y’all ❤️ #MedTwitter #Match2024 IMG_stories


We didn’t come this far to only come this far. Keep going! Grateful for the opportunity to apply for #Match2024 #MedTwitter IMG_stories Inside The Match



Studying for step 3 with a newborn is wild and should be considered an extreme sport #Match2024 IMG_stories

Unmatched this cycle. Trying to stay positive and working on strengthening my application for #match2025 . Looking for mentors/guidance to get to an IM categorical/TY/prelim. Non-USIMG, Step 1, 2 and 3 done. Inside The Match The Unmatched MD Asim